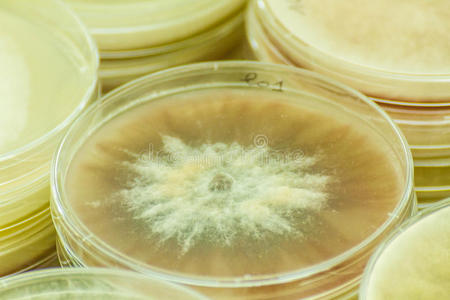
链格孢petroleum石油盘照片

链格孢菌图片
链格孢
图片尺寸633x442
链格孢菌(斜面)
图片尺寸376x208链格孢
图片尺寸800x640
链格孢霉过敏性真菌
图片尺寸700x467
显微镜下链格孢霉菌丝和孢子形态
图片尺寸472x351
室内过敏源:链格孢到底是什么?
图片尺寸640x578链格孢
图片尺寸630x1120
链格孢菌
图片尺寸1424x1920alternariaapp链格孢属真菌
图片尺寸1015x1015
链格孢属
图片尺寸296x469
【皮肤霉菌学】链格孢菌(链格菌,alternaria)
图片尺寸500x377链格孢霉菌
图片尺寸450x353
交链链格孢26℃在sda上的菌落形态(中国医学科学院皮肢病研究所
图片尺寸1000x680
玉米链格孢菌叶枯病
图片尺寸431x308
链格孢petroleum石油盘照片
图片尺寸450x300
交替链格孢菌在营养培养基上的菌落图解和照片照片
图片尺寸450x300
链格孢属(alternaria)
图片尺寸750x1335
交替链格孢菌在营养培养基上的菌落图解和照片
图片尺寸480x320
链格孢霉,过敏性真菌照片
图片尺寸600x300
链格孢
图片尺寸1230x1489